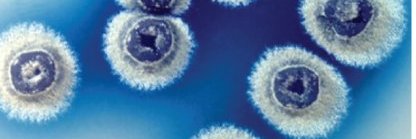
Glasgow Microbiology Collective banner

Glasgow Microbiology Collective retweetledi

What a fantastic #glasgowmicro22 meeting this year! Such a fantastic and diverse range of topics, really showcases the importance of microbiology! Very well done by the organisers and all of the speakers!! 👏👏👏
English